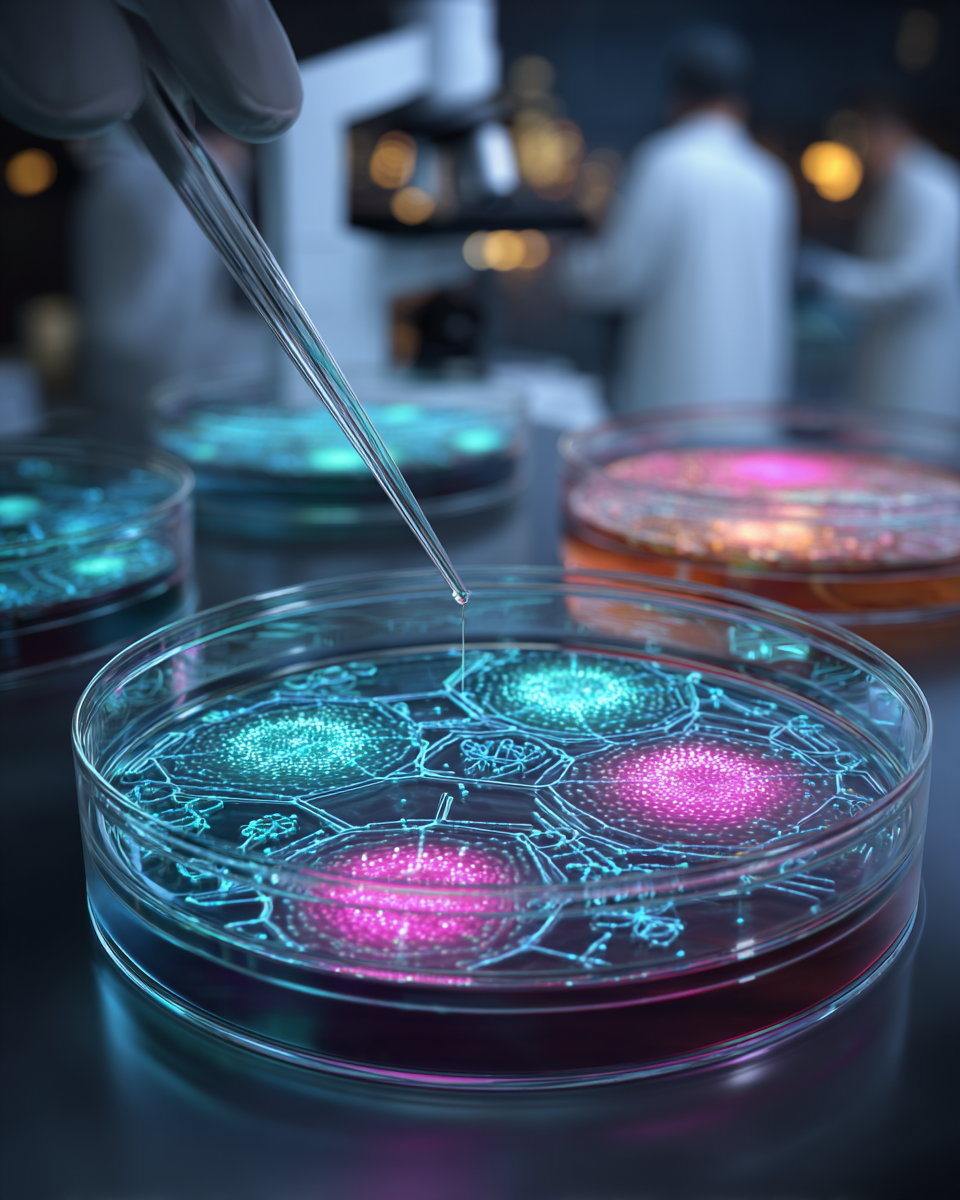

Quem acompanha as redes sociais do Instituto Vencer o Câncer sabe que informação faz toda a diferença para a prevenção e tratamento do câncer. Por isso, convidamos grandes especialistas do país para juntos discutirmos temas como a vacinação para prevenir diversos tipos de tumores, novos medicamentos, tratamentos e formas de diagnóstico e o acesso a eles tanto no Sistema Único de Saúde quanto na rede privada.
Não perca Fórum BandNews Como Vencer o Câncer!
É nesta segunda-feira, dia 9 de maio, às 19 horas, ao vivo no canal do YouTube Band Jornalismo
Na quarta-feira, dia 11 de maio, às 23h30, veja o compacto na TV no canal BandNews.
Veja quem vai estar presente e quais os temas dos debates.
Vacinas – mitos e verdades
- HPV: tabus que envolvem a vacina e o projeto do Instituto Vencer o Câncer em prol da vacinação contra o papilomavírus que é a principal causa de câncer de colo de útero, entre outros tipos.
- Vacinação HPV para prevenção do câncer.
- Vacinação para pacientes oncológicos.
Debatedores
Dr. Antonio Buzaid – oncologista e fundador do Instituto Vencer o Câncer.
Dr. Fernando Maluf – oncologista e fundador do Instituto Vencer o Câncer.
Dr. Renato Kfouri – pediatra, infectologista e primeiro secretário da SBIm – Sociedade Brasileira de Imunizações.
Dra. Carla Domingues – epidemiologista, foi coordenadora do Programa Nacional de Imunizações do Ministério da Saúde de 2011 a 2019.
Futuro para vencer o câncer é hoje
- Câncer de pulmão: novidades no tratamento.
- Cânceres mais incidentes: próstata para os homens e mama para mulheres. Qual a relação entre câncer de mama e o de ovário?
- Novos tratamentos: medicina de precisão, medicina personalizada, testes genéticos, terapias inovadoras e a qualidade de vida.
Debatedores
Dr. Antonio Buzaid – oncologista e fundador do Instituto Vencer o Câncer.
Dr. Bernardo Garicochea – oncologista hematologista – Grupo Oncoclinicas.
Dr. Carlos Barrios – oncologista – diretor do Latin American Cooperative Oncology Group (LACOG)
SUS x Sistema de Saúde Suplementar
- Expectativa e realidade
- Políticas públicas x acesso
- Projeto do Instituto Vencer o Câncer: ações para transformar o atual cenário da oncologia no Brasil.
Debatedores
Dr. Fernando Maluf – oncologista e fundador do Instituto Vencer o Câncer.
Dr. Denizar Vianna – Pró-Reitor de Saúde – Universidade do Estado do Rio de Janeiro
Gabriela Tannus – economista da saúde e diretora da AXIA.BIO Life Sciences International.
Esta edição do Fórum BandNews Como Vencer o Câncer é uma realização do Instituto Vencer o Câncer com patrocínio e apoio Bristol-Myers Squibb, Janssen, GSK, Libbs, Roche, Astrazeneca, Sanofi.